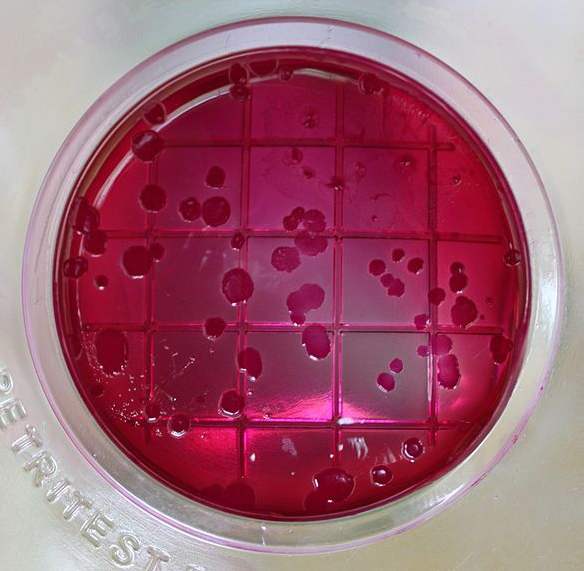
Bildbeschreibung und Urheberrecht

Generationszeiten
Beispiele
© 2016
- 2025
Basiswissen
Generationszeit ist definiert als die Zeit, die etwas benötigt, um sich einmal vollständig fortupflanzen. Bei einigen Bakterien liegt die Zeit im Minutenbereich, bei Säugetieren deutlich darüber. Hier stehen einige Beispiele.
Einzeller
- 20 Minuten 👉 Escherichia coli
- 6 bis 8 Stunden 👉 Kragengeißeltierchen
- 4 bis 18 Stunden Treponema pallidum (externer Link)
- 18 Stunden Mycobacterium tuberculosis (externer Link)
Aga-Kröte
- Die Aga-Kröte wurde um 1935 im Nordosten Australien angesiedelt.
- Man wollte mit ihr Schädlinge auf Zuckerrohrplantagen bekämpfen.
- Seitdem breitet sich die Kröte mehr oder minder exponentiell aus.
- Wegen ihrer Robustheit verändert sie stark das heimische Ökosystem.
- Die Generationszeit lag um 2018 bei etwa 3 Jahren.
- Mehr unter 👉 Aga-Kröte
Menschen
Bei Menschen gibt die Generationszeit die durchschnittliche Zeit zwischen zwei Generationen an. Sie liegt bei etwa 25 Jahren. Siehe auch 👉 Generation